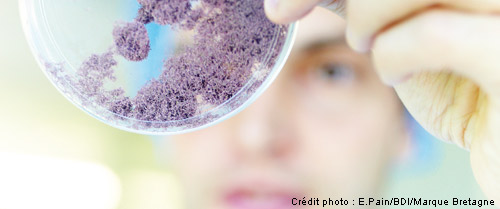

Research
Search for a skill
Visit the directory of research laboratories in Brittany
The UEB – coordinator of close and effective scientific cooperation
The UEB organises close and effective scientific cooperation between its member institutions, and in doing so develops still further this Breton tradition which is already working successfully in numerous joint interdisciplinary activities, such as joint doctoral schools, scientific interest groups, and joint research units.
Objective
- To increase the international standing of research and to permanently establish Brittany as a region of knowledge and innovation.
- In order to achieve this, the UEB has equipped itself with additional tools to supplement national and European tools so as to strengthen the structuring of its networked research departments and to enhance their participation in European and international programmes.
More about UEB research tools
Subject areas
Within the framework of the 2008-2011 strategic plan, and in line with Brittany’s regional research strategy, 6 subject areas have been identified.
- Biology, and Health
- Marine Science and Technology
- Agronomy, Environment, and Sustainable Development
- Matter, Materials, and Nanosciences
- Mathematical Sciences, and Information and Communication Technology
- Arts, Humanities and Social Sciences, Economics, and Law
Consult the directory of research units
The Conseil Scientifique (CS – Scientific Committee)
The CS is a consultative body whose function is to put forward guidelines as to research direction and to draw up recommendations to put to the UEB’s governing body, the Conseil d’Administration, on joint research policy. It also promotes high-quality scientific work which can contribute to research excellence in Brittany and to its international standing.
It facilitates joint action which is consistent with the research directions of member institutions, and validated by the different supervisory bodies of the research units.
The Conseil Scientifique’s opinions on the UEB’s activities are sought by the president of the Conseil d’Administration. This is particularly so as regards the CS’s contribution to the regional research strategic action plan, but it can also be asked for its opinions on other projects.